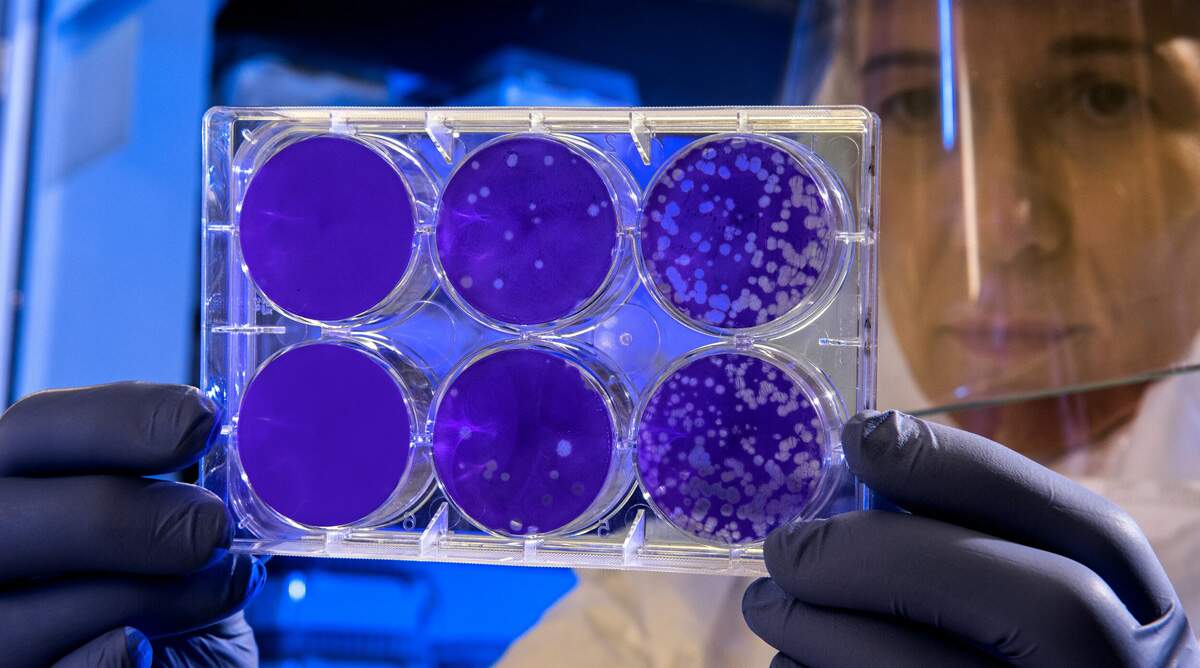

Προς λήξη συναγερμού βαίνει το πρώτο ύποπτο κρούσμα του ιού της ευλογιάς των πιθήκων που αφορούσε σε Βρετανό που έκανε διακοπές στην Κεφαλονιά. Πηγές του υπουργείου Υγείας αναφέρουν ότι το δείγμα του ύποπτου κρούσματος βρέθηκε θετικό για τον ιό της ανεμοβλογιάς σε δύο επαναλαμβανόμενους ελέγχους.
Στην ίδια ανακοίνωση προέβη το βράδυ της Κυριακής και ο ΕΟΔΥ, επισημαίνοντας ότι ο ιός της Ανεμοβλογιάς παρότι περιλαμβάνει το συνθετικό -pox είναι διαφορετικός από τον ιούς που προκαλούν Ευλογιά ή Ευλογιά των πιθήκων. Υπάρχει συνάφεια αναφορικά με τα συμπτώματα και την εμφάνιση δερματικών αλλοιώσεων που προκαλούνται από την Ανεμοβλογιά και την Ευλογιά, Ευλογιά των πιθήκων.
Υπενθυμίζεται ότι ο Βρετανός τουρίστας παραμένει νοσηλευόμενος στο νοσοκομείο ΑΤΤΙΚΟΝ όπως και η φίλη του η οποία είναι ασυμπτωματική. Ο ΕΟΔΥ επισημαίνει ακόμα ότι η Ευλογιά έχει εκριζωθεί από τον ανθρώπινο πληθυσμό από το 1980 ενώ η Ανεμοβλογιά αποτελεί μια συχνή νόσο που προκαλεί περίπου 4 εκατομμύρια λοιμώξεις σε παιδιά. Για την Ανεμοβλογιά υπάρχει διαθέσιμο εμβόλιο και προκαλεί ηπιότερη νόσο από την Ευλογιά.